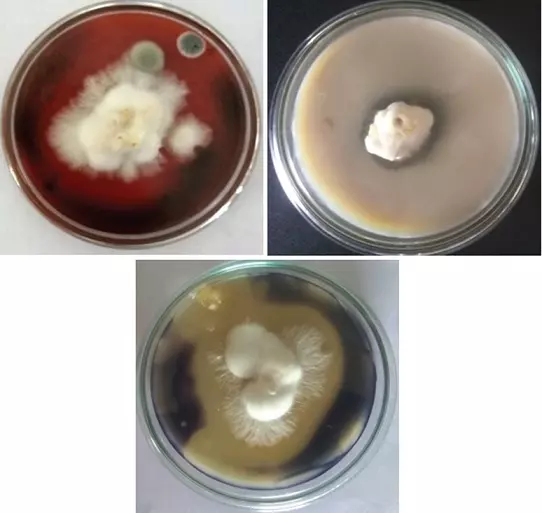
Graphical Abstract

Isolation and optimization of alkaline protease producing Bacteria from undisturbed soil of NE-region of India falling under Indo-Burma biodiversity hotspots
Onkar Nath Tiwari, Thiyam Bidyababy Devi, Kangjam Sarabati Devi, Gunapati Oinam, Thingujam Indrama, Keithellakpam Ojit, Oinam Avijeet, Lakreiphy Ningshen
DOI: 10.7324/JABB.2015.3406Pages: 025-031

Effect of cypermethrin, a pyrethroid insecticide on dynamics of soil microflora
Bijay Kumar Sethi, Subhashree Pradhan, Narayan Behera, Santi Lata Sahoo
DOI: 10.7324/JABB.2015.3504Pages: 019-025

Treatment of cashew extracts with Aspergillopepsin reduces IgE binding to cashew allergens
Cecily B. DeFreece, Jeffrey W. Cary, Casey C. Grimm, Richard L. Wasserman, Christopher P Mattison
DOI: 10.7324/JABB.2016.40201Pages: 001-010

Chitinolytic efficacy and secretion of cell wall degrading enzymes from Trichoderma spp. in response to phyto-pathological fungi
Dinesh K Khatri, Durgesh Nandini Tiwari, Himanshu S Bariya
DOI: 10.7324/JABB.2017.50601Pages: 1-8

Optimization of fermenting medium by statistical method for production of alkaline protease by Bacillus licheniformis MZK05M9
Md. Arafat Al Mamun, Md. Mahmuduzzaman Mian, Mohammad Saifuddin, Shakila Nargis Khan, Md. Mozammel Hoq
DOI: 10.7324/JABB.2017.50604Pages: 24-28

Sequestration and purification of essential enzyme from Pleurotus florida compost waste and its application studies
S Karthika Devi, N Prabhu, S Monika, N M Swapna, S Vaishali, T Gajendran
DOI: 10.7324/JABB.2020.80111Pages: 64-68
Purification and characterization of extracellular alkaline protease from Streptomyces sp. LCJ12A isolated from Pichavaram mangroves
M. Parthasarathy, J. Joel Gnanadoss
DOI: 10.7324/JABB.2020.80103Pages: 15-20

Determination of the activity and kinetics parameters of proteases in the crude plant extracts of Mentha piperita L. and Thymus capitatus L.
Omar Mohammad Atrooz, Fatmah Nasser Alomari
DOI: 10.7324/JABB.2020.80606Pages: 33-37

Optimization of amylase and protease production from oyster mushrooms koji (Pleurotus spp.) using response surface methodology
Nguyen Thi Ngoc Giang, Tran Van Khai, Nguyen Minh Thuy
DOI: 10.7324/JABB.2021.100107Pages: 54–61

Media optimization for the production of alkaline protease by Bacillus cereus PW3A using response surface methodology
Gururaj B. Tennalli, Soumya Garawadmath, Lisa Sequeira, Shreya Murudi, Vaibhavi Patil, Manisha N. Divate, Basavaraj S. Hungund
DOI: 10.7324/JABB.2022.100403Pages: 17-26

Bromelain improves the growth, biochemical, and hematological profiles of the fingerlings of Nile Tilapia, Oreochromis niloticus
Jhanani Gopalraaj, John Britto Sagaya Raj, Krishnakumar Velayudhannair, Latha Chandrakas
DOI: 10.7324/JABB.2022.10s207Pages: 73-77

Isolation and partial characterization of serine proteases from jellyfish of the Antarctic region
Nataliia Raksha, Teyiana Halenova, Tetiana Vovk, Tetiana Beregova, Tetiana Maievska, Victor Tomchuk, Olexiy Savchuk, Ludmila Ostapchenko
DOI: 10.7324/JABB.2023.110214Pages: 144-150

Investigation of optimal parameters for aspartic protease production from Aspergillus terreus using solid-state fermentation
Sadeq Fenjan Hasnawi, Alaa Jabbar Abd Al-Manhel, Zena Kadhim AL-Younis
DOI: 10.7324/JABB.2024.163839Pages: 234-240

Screening and characterization of thermostable protease-producing bacteria isolated from slaughter site soil samples from Southern India
Nafila Puthiya Punnarath, Anjana Meppat, Anitha Subash, Servin Wesley Ponraj, Shobana Arunachalam
DOI: 10.7324/JABB.2024.193529Pages: 159-168

Screening of Trichoderma isolates from Punjab and Himalayan region for hydrolytic enzyme production
Ranjna Kumari, Mayukh Sarkar, T. S. Archana, Vipul Kumar, Swapna Rekha Panda, Amol Kantilal Wagh
DOI: 10.7324/JABB.2026.292854Pages: 108-114
